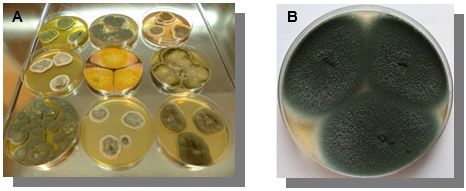

Wyszukiwanie w bazie wiedzy
OZNACZANIE SZKODLIWYCH CZYNNIKÓW MIKROBIOLOGICZNYCH NA STANOWISKACH PRACY W ZAKŁADACH PRODUKUJĄCYCH I PRZETWARZAJĄCYCH BIOSUROWCE DO CELÓW ENERGETYCZNYCH
Narażenie zawodowe na szkodliwe czynniki biologiczne oraz pyły występuje w wielu sektorach gospodarki narodowej. Ze względu na charakter wykonywanej pracy i specyfikę środowiska, narażenie na tego rodzaju czynniki jest szczególnie powszechne wśród pracowników branży energetycznej (ryc.1). W Polsce, około 150 tys. pracowników pracuje w warunkach zagrożenia czynnikami biologicznymi w zakładach produkujących i przetwarzających biosurowce do celów energetycznych. Są to pracownicy np.:
- przedsiębiorstw produkujących biosurowce pochodzenia roślinnego (produkcja pelletu, brykietu, itp.);
- przedsiębiorstw pozyskujących i przetwarzających drewno;
- przedsiębiorstw zajmujących się uprawą roślin energetycznych;
- przedsiębiorstw transportujących biosurowce;
- elektrowni i elektrociepłowni przetwarzających biosurowce do celów energetycznych;
- przedsiębiorstw produkujących paliwo z biomasy.

Ryc. 1. Rozładunek biosurowców
Ostatnie doniesienia literaturowe jednoznacznie wskazują na to, że praca związana z przetwarzaniem biosurowców roślinnych i zwierzęcych wiąże się z narażeniem pracowników na liczne szkodliwe czynniki biologiczne.
Stężenia aerozolu bakteryjnego i grzybowego na tego rodzaju stanowiskach pracy mogą kształtować się na poziomie 104-106jtk/m3. Narażenie na tak wysokie stężenia aerozoli biologicznych (bioaerozoli) może powodować inicjację wielu chorób o charakterze alergicznym, zapalnym i toksycznym, takich jak przewlekłej obturacyjnej choroby płuc (POChP), astmy oskrzelowej, przewlekłego zapalenia oskrzeli, nadreaktywności oskrzeli, alergicznego zapalenia pęcherzyków płucnych (AZPP), syndromu toksycznego wywołanego pyłem organicznym (organic dust toxic syndrome, ODTS) oraz podrażnień błon śluzowych, spojówek i skóry pracowników. Stąd też, tak ważne jest podjęcie odpowiednich działań prewencyjnych i profilaktycznych na tego rodzaju stanowiskach pracy oraz wyposażenie pracowników w dostosowane do poziomu narażenia środki ochrony indywidualnej.
Największe zagrożenie dla zdrowia pracowników związanych z produkcją i przetwarzaniem biosurowców stanowią grzyby pleśniowe z rodzaju Aspergillus, Penicillium, Alternaria, Cladosporium i Mucor (ryc.2).
Ryc.2. Kolonie grzybów pleśniowych na płytkach z podłożem MEA (Malt Extract Agar):
A - kolonie różnych gatunków grzybów, B - kolonie Aspergillus fumigatus.
Pracownicy mający kontakt z spleśniałymi biosurowcami mogą być także narażeni na działanie β-glukanów. Są to komponenty ściany komórkowej większości grzybów (również niektórych bakterii, roślin wyższych i glonów). β-glukany mogą powodować u narażanych osób podrażnienie oczu i gardła, kaszel, swędzenie skóry, atopie, wzrostem poziomu MPO (peroksydazy krwinek białych) w surowicy i alergiczne zapalenie pęcherzyków płucnych (AZPP). W pyle pochodzenia roślinnego i zwierzęcego mogą również licznie występować bakterie z rodzajów Bacillus, Streptomyces, Pantoea, Rahnella i Acinetobacter.
JAK BADAĆ SZKODLIWE CZYNNIKI BIOLOGICZNE?
Uwzględniając różnorodność materiałową i źródła pochodzenia surowców, w tych specyficznych środowiskach pracy pod względem mikrobiologicznym mamy do czynienia z „mieszaniną sygnałów z wielu źródeł”. A ich precyzyjne rozpoznanie i rozróżnienie ma znaczenie kluczowe w prowadzeniu skutecznej profilaktyki na stanowisku pracy. Jednakże, wykonywanie oznaczeń mikrobiologicznych na stanowiskach pracy związanych z narażeniem na pył organiczny pochodzenia roślinnego i zwierzęcego wciąż nastręcza wielu trudności diagnostycznych i logistycznych w wielu polskich laboratoriach mikrobiologicznych (ryc.3). Wynikają one przed wszystkim z nieodpowiedniego wyboru stanowisk pomiarowych, rodzaju próbek, a także wyboru metody pomiaru i analizy. Należy podkreślić, iż specyfika wykonywanych czynności zawodowych, jak również rodzaj szkodliwych czynników biologicznych występujących w tego rodzaju środowiskach pracy warunkują wybór stanowisk pomiarowych oraz metod pomiaru (ryc. 4).
UWAGA!!! Do wykrywania obecności czynników biologicznych w środowisku pracy i określenia rozmiarów ekspozycji, największe znaczenie ma badanie bioaerozoli. Istotne może być również mikrobiologiczne badanie próbek biosurowców, a także wymazów z instalacji przemysłowej i rąk pracowników.

Ryc.3. Fazy badań mikrobiologicznych na stanowiskach pracy.

Ryc. 4. Rodzaje badanych próbek.
BADANIE BIOAEROZOLU
Do pomiaru bioaerozoli można zastosować dwie strategie pomiarowe: stacjonarną i osobistą. W przypadku pomiaru stacjonarnego, miernik (impaktor, impinger) ustawia się na stanowisku pomiarowym na wysokości 1,0-1,5m nad powierzchnią podłogi/gruntu dla poboru bioaerozolu ze strefy oddechowej człowieka (położenie jamy ustnej i nosowej) (ryc.3). Natomiast lekkie mierniki do pomiaru osobistego (np. Button Sampler czy głowica GSP i CIS) są mocowane na specjalnych szelkach/paskach, zakładanych pracownikowi tak, aby głowica z filtrem (jako powierzchnią wychwytu cząstek biologicznych) znajdowała się na wysokości strefy oddechowej człowieka. Po wykonaniu pomiaru techniką impakcyjną, płytki z podłożem mikrobiologicznym inkubuje się przez odpowiedni okres czasu (zwykle od 2-7 dni), a po zliczeniu kolonii oraz uwzględnieniu objętości próbki wyznacza się stężenie mikroorganizmów w jednostkach tworzących kolonie (jtk) w 1m3 powietrza [jtk/m3]. Należy zaznaczyć, że liczbę kolonii mikroorganizmów wyrosłych na podłożu każdorazowo weryfikuje się w oparciu o tablicę konwersyjną opracowaną przez producenta użytego impaktora. W przypadku impkacji do cieczy, po pomiarze część uzyskanej zawiesiny wysiewa się na płytki Petriego z odpowiednimi podłożami. Po pomiarze z użyciem głowic filtracyjnych, filtry pomiarowe poddawane są ekstrakcji w odpowiednim roztworze (np. soli fizjologicznej z 0,05% dodatkiem Tweenu 80). W celu zliczenia mikroorganizmów żywych otrzymaną zawiesinę wysiewa się na płytki Petriego z odpowiednimi podłożami, a stężenie mikroorganizmów podaje się w jednostkach - jtk/m3.
Analiza jakościowa mikroorganizmów bakteryjnych i grzybowych wyizolowanych z próbek środowiskowych (powietrza, biomasy, wymazów z powierzchni oraz wymazów z rąk) powinna być przeprowadzona w 3 kolejnych etapach, polegających na obserwacjach makro- i mikroskopowych oraz charakterystyce biochemicznych wyizolowanych szczepów. Do identyfikacji mikroorganizmów można również zastosować metody oparte o PCR (z ang. polymerase chain reaction) oraz technikę różnicowania genetycznego np. RAPD-PCR, PFGE, DGGE, RFLP-PCR, ADSRRS oraz ITS-PCR.

Ile pobrać próbek bioaerozolu?
Pomiary bioaerozolu z użyciem głowic filtracyjnych filtrów, impaktorów lub impingerów powinny być wykonywane w dwóch powtórzeniach na każdym stanowisku pomiarowym.
Liczba stanowisk pomiarowych
Liczba stanowisk pomiarowych powinna być adekwatna do liczby stanowisk pracy związanych z narażeniem na szkodliwe czynniki mikrobiologiczne. Przed zaplanowaniem pomiarów warto przyjrzeć się układowi badanych hal/pomieszczeń i wyznaczyć stanowiska pomiarowe znajdujące się w miejscach najbardziej narażonych na kontakt ze szkodliwym czynnikiem biologicznym na danym stanowisku pracy (np. przy maszynach, taśmociągach).
UWAGA!!! Planując liczbę stanowisk pomiarowych należy uwzględnić oprócz stanowisk pracy wzdłuż linii technologicznej czy też pionu biurowego, przynajmniej jedno stanowisko tzw. tła zewnętrznego. Punkt ten powinien być zlokalizowany około 50m poza zakładem pracy. Tego rodzaju pomiar dostarczy informacji o wpływie zanieczyszczeń z powietrza atmosferycznego na stężenia mikroorganizmów na stanowiskach pracy.
BADANIE BIOSUROWCÓW
Badanie biosurowców pod kątem obecności szkodliwych czynników mikrobiologicznych odgrywa znaczącą rolę w monitoringu zanieczyszczenia mikrobiologicznego na stanowiskach pracy. Należy zaznaczyć, że badane próbki biosurowców muszą być reprezentatywne dla badanego materiału lub jego dostawy/partii. Stąd też bardzo ważne jest zaplanowanie liczby próbek. W przypadku biomasy, można pobrać kilka próbek pierwotnych o mniejszej objętości (np. 0,5kg), które następnie są łączone w większą próbkę (minimum 3kg). Należy podkreślić, że różne rodzaje biosurowców mogą mieć różną fakturę i kształt, który może uniemożliwić pobór do standardowych sterylnych pojemników czy woreczków.
Stanowiska poboru próbek powinny być równomiernie rozproszone po całym obszarze próbkowania (np. magazyn, hala), z którego mają być pobrane próbki. Liczba próbek pierwotnych musi być na tyle duża, aby umożliwić uzyskanie reprezentatywnej średniej (minimum 3). Po ekstrakcji biosurowców w buforze płuczącym, z uzyskanej zawiesiny wykonuje się szereg rozcieńczeń, a następnie wysiewa inokulum na płytki Petriego z odpowiednimi podłożami mikrobiologicznymi. Stężenie mikroorganizmów bateryjnych i grzybowych oblicza się w jednostkach tworzących kolonie (jtk) na 1 gram surowca [jtk/g]. W niektórych przypadkach, stężenie mikroorganizmów można również obliczać w jtk na 1 litr surowca [jtk/l].
BADANIE CZYSTOŚCI POWIERZCHNI UŻYTKOWYCH I RĄK
Badanie czystości powierzchni metodą szablonową służy do określenia czystości mikrobiologicznej powierzchni roboczych o dużej i stosunkowo jednorodnej powierzchni, np. blaty robocze, ściany, podłogi i fragmenty maszyn. W tym celu do badanej powierzchni przykłada się sterylny szablon o powierzchni otworu wewnętrznego 100cm2, a następnie przeciera wymazówką (o nylonowej lub bawełnianej końcówce, zwilżonej odpowiednim płynem - sterylną wodą lub solą fizjologiczną) obszar ograniczony szablonem kilkukrotnie. Wymazówkę wkłada się do probówki z płynem płuczącym. Z uzyskanej zawiesiny wykonuje się szereg rozcieńczeń, a następnie wysiewa inokulum na płytki Petriego z podłożami mikrobiologicznymi. Stężenie mikroorganizmów wyznacza się w jednostkach tworzących kolonie (jtk) na 1cm2 badanej powierzchni. W przypadku powierzchni trudno dostępnych (np. anemostaty), o porowatych i nieregularnych kształtach stosuję się metodę wymazu z powierzchni bez ograniczenia szablonu. Stężenie mikroorganizmów wyznacza się w jednostkach tworzących kolonie (jtk) na całą badanej powierzchnię. W wielu zakładach pracy coraz częściej bada się czystość mikrobiologiczną rąk pracownika. W tym celu pobiera się wymazy z obu dłoni pracownika. Sposób pomiaru i analiza tego rodzaju próbek jest podobna jak w przypadku oceny czystości powierzchni.
PIŚMIENNICTWO
- Dutkiewicz J, Śpiewak R, Jabłoński L, Szymańska J. Biologiczne czynniki zagrożenia zawodowego. Klasyfikacja, narażone grupy zawodowe, pomiary, profilaktyka. IMW, Lublin 2007.
- Gołofit-Szymczak M., Ławniczek-Wałczyk A.: Biomasa jako źródło zagrożeń biologicznych, Bezpieczeństwo Pracy , 2011, 12, 17-19.
- Krzyściak P, Skóra M, Macura AB. Atlas grzybów chorobotwórczych człowieka. MedPharm, Wrocław 2011.
- Lacey J, Dutkiewicz J. Bioaerosols and occupational lung disease. J Aerosol Sci 1994, 25(14): 1371-1404.
- Ławniczek-Wałczyk A, Gołofit-Szymczak M, Cyprowski M, Górny RL. Exposure to harmful microbiological agents during the handling of biomass for power production purposes. Med Pr 2012, 63(4):395-407.
- Madsen AM, Märtensson L, Schneider T, Larsson L. Microbial dustiness and particle release of different biofuels. Ann Occup Hyg 2004, 48:327-338.
- Madsen AM, Schlünssen V, Olsen T, Sigsgaard T, Avci AH. Airborne fungal and bacterial components in PM1 dust from biofuel plants. Ann Occup Hyg 2009, 53(7): 749-757.
- Madsen AM. Exposure to airborne microbial components in autumn and spring during work at Danish biofuel plants. Ann Occup Hyg 2006, 50:821-831.
- Polska Norma PN-EN 13098 (2007): Powietrze na stanowiskach pracy - Wytyczne dotyczące pomiaru mikroorganizmów i endotoksyn zawieszonych w powietrzu. Polski Komitet Normalizacyjny, Warszawa.
- Polska Norma PN-EN 14031 (2006): Powietrze na stanowiskach pracy - Oznaczanie endotoksyn zawieszonych w powietrzu. Polski Komitet Normalizacyjny, Warszawa.
- Polska Norma PN-EN 14583 (2008): Powietrze na stanowiskach pracy - Wolumetryczne poborniki bioaerozolu - wymagania i metody testowania. Polski Komitet Normalizacyjny, Warszawa.
- Rozporządzenie Ministra Gospodarki z dnia 18 października 2012 r. w sprawie szczegółowego zakresu obowiązków uzyskania i przedstawienia do umorzenia świadectw pochodzenia, uiszczenia opłaty zastępczej, zakupu energii elektrycznej i ciepła wytworzonych w odnawialnych źródłach energii oraz obowiązku potwierdzania danych dotyczących ilości energii elektrycznej wytworzonej w odnawialnym źródle energii (Dz.U. z 2012 r. poz. 1229).
- Rozporządzenie Ministra Zdrowia z dnia 22.04.2005 r. w sprawie szkodliwych czynników biologicznych dla zdrowia w środowisku pracy oraz ochrony zdrowia pracowników zawodowo narażonych na te czynniki (Dz.U. 2005, nr 81 poz. 716 ze zm.: Dz.U. 2008, nr 48 poz. 288).
- Rylander R. Organic dusts - from knowledge to prevention. Scand J Work Environ Health 1994, 20: 116-122.
- Samson RA, Hoekstra ES, Frisvad JC. Introduction to food - and airborne fungi. 7th edition. Centraalbureau voor Schimmelcultures, Utrecht 2004.